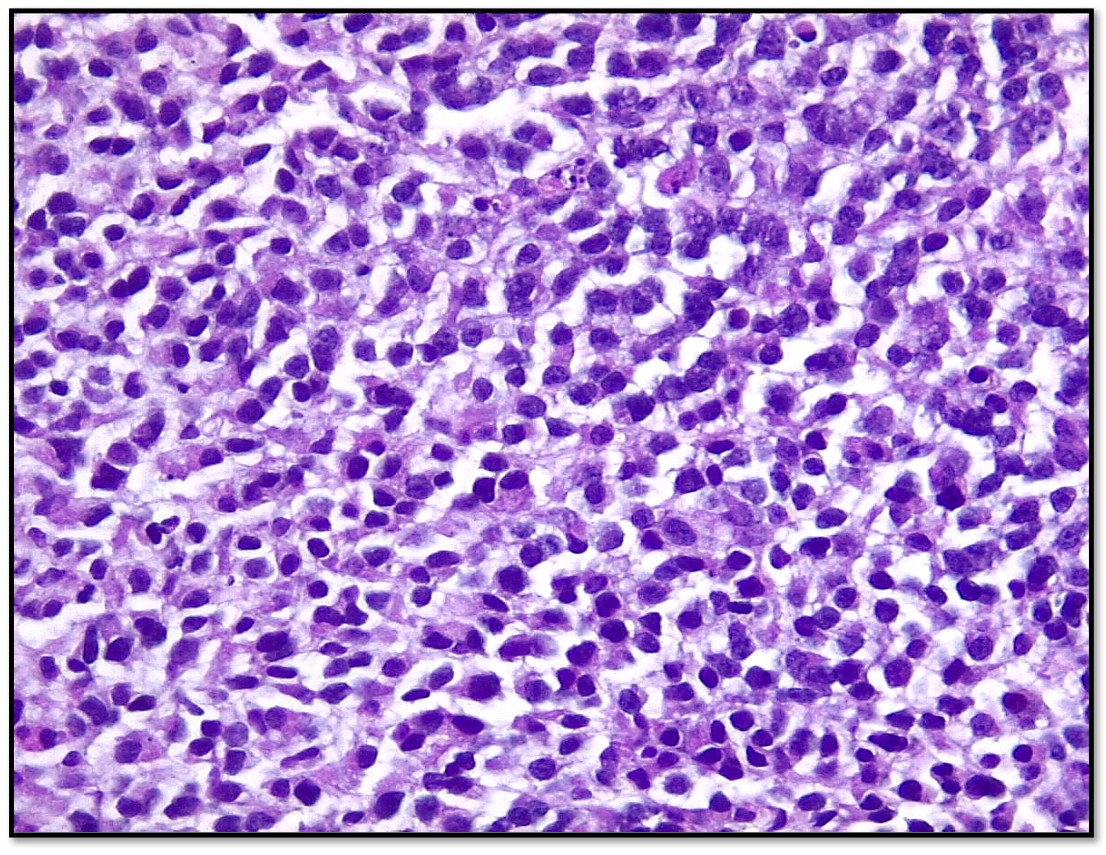

Cortesía:
Dra. Gloria Celina Mairena Gutiérrez
Alta Especialidad en Hematopatología - Inmunohistoquímica
Hospital Español, 2019-2020.
Resumen clínico:
Femenina, 36 años.
Padecimiento actual: inició en 2021 con aumento de volumen en el músculo gastrocnemio derecho, inicialmente sin dolor. En marzo 2022 aumento de dolor, acompañado y dificultad a la marcha.

USG con toma de biopsia: se reporta tumor ocupativo en músculo gastrocnemio de 10.2x5.5 cm, de bordes regulares y con aparente cápsula, de consistencia sólida-heterogénea y de predominio hipoecoico. Al aplicar Doppler color con vascularidad intralesional. Se realiza biopsia con aguja de corte.

PREGUNTAS
1. ¿Cuál es tu diagnóstico?
A. Sarcoma de Ewing
B. Rabdomiosarcoma
C. Linfoma plasmablástico
D. Condrosarcoma Mesenquimal
2. ¿Cuáles son los diagnósticos diferenciales?
A. Sarcoma de Ewing
B. Linfoma plasmablástico
C. Condrosarcoma Mesenquimal
D. Rabdomiosarcoma
3. ¿Qué panel de inmunohistoquímica realizarías?
A. Proteína S-100, CD 99, NKX2.2, SOX 9 Y CKAE1/AE3
B. CD138, CD79a, MUM-1, c-MYC
C. SMA, S-100 Y SOX 9
D. Miogenina, MyoD1, CD56
4. ¿Cuál es el comportamiento epidemiológico de esta lesión?
A. Frecuencia del 20% de este grupo de neoplasia y se presenta entre los 20 y 30 años de edad
B. Corresponde al 5% de este grupo de lesiones y predomina en los adultos jóvenes
C. Predomina en los niños y corresponde al 1% de este grupo de lesiones
D. Representa del 2-4% de este grupo de lesión y se observa entre la 2ª y 3ª décadas de la vida
CONDROSARCOMA MESENQUIMATOSO
Los sarcomas de células redondas y pequeñas (SRCS) representan la mayoría de las neoplasias malignas sólidas en el grupo de edad pediátrica y forman parte del grupo de tumores malignos caracterizados por una presentación clínica heterogénea y características microscópicas superpuestas de células primitivas pequeñas y redondas.
Recientemente se estableció un subconjunto genéticamente de sarcomas de células redondas indiferenciadas de tejidos blandos y hueso, este grupo de sarcomas incluye: tumor desmoplásica de células redondas pequeñas, sarcoma sinovial poco diferenciado, rabdomiosarcoma alveolar, condrosarcoma mesenquimatoso y osteosarcoma de células pequeñas.
Aunque esas entidades comparten características clínicas y citomorfológicas, no pueden clasificarse en función de la presentación clínica y la morfología únicamente. Las características citológicas claves y en ocasiones distintivas reducen el número de diagnósticos diferenciales y ayudan a seleccionar las pruebas auxiliares necesarias para el diagnóstico final. Un diagnóstico
Los condrosarcomas mesenquimales (MC) son formas raras y agresivas de condrosarcoma. Es una neoplasia mesenquimatosa bifásica maligna con componente de cartílago hialino bien diferenciado.
Por lo general se presenta en adolescentes y adulto jóvenes, con ligero predominio del sexo femenino.
Los sitios anatómicos mas afectados es hueso, tejidos blandos (cabeza y cuello), sitios intracraneales y órganos viscerales. La sintomatología depende del sitio anatómico afectado, son tumores de crecimiento lento.
Macroscópicamente se presentan como tumores carnosos, firmes, bien delimitados y lobulados; colores grisáceos y con calcificaciones.
Microscópicamente se presentan como tumores sólidos y bifásicos, compuesto por células redondas, pequeñas y azules, dispuestos en sabanas con necrosis y actividad mitosica elevada; y un componente de cartílago hialino maduro.
Por inmunohistoquímica se debe realizar un panel que englobe las neoplasias de células redondas pequeñas y azules, de acuerdo con la edad y a la morfología observada. Por inmunohistoquímica este sarcoma comparte un inmunofenotipo similar al sarcoma de Ewing, ya que comparten expresión NKX2.2 y CD99; sin embargo, la expresión de SOX-9 y S-100 en ambos componentes tanto maduro e inmaduro ayuda a diferenciarlo de este sarcoma. Otro anticuerpo que podría ser de mucha utilidad para diferenciar ambos sarcomas, seria utilizar NKX3.1 en los condrosarcomas mesenquimatosos, ya que se ha demostrado una sensibilidad del 80% y una especificidad del 100%.
Siempre se recomienda realizar estudios citogenéticos para confirmar y excluir otras neoplasias. La mayoría de los casos tienen fusiones HEY-NCOA2 ; sin embargo , también se ha descrito la fusión IRF2BP2-CDX1
En conclusión, la comprensión de la presentación clínica, la correlación con los estudios radiológicos, una adecuada valoración de la morfología con sus características distintivas y la ayuda de pruebas auxiliares guiadas, son esenciales para hacer un diagnóstico correcto.